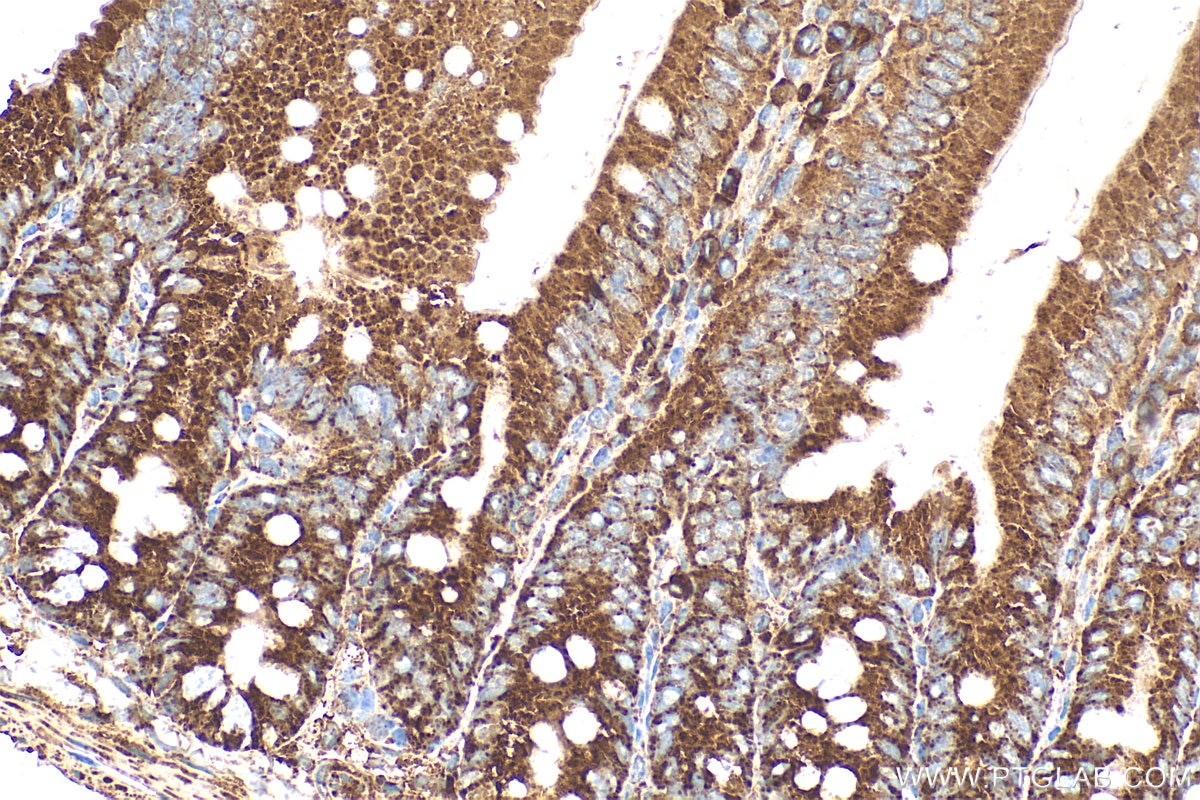

Tested Applications
| Positive WB detected in | mouse testis tissue |
| Positive IP detected in | mouse testis tissue |
| Positive IHC detected in | mouse small intestine tissue, human brain tissue, human small intestine tissue Note: suggested antigen retrieval with TE buffer pH 9.0; (*) Alternatively, antigen retrieval may be performed with citrate buffer pH 6.0 |
Recommended dilution
| Application | Dilution |
|---|---|
| Western Blot (WB) | WB : 1:500-1:2000 |
| Immunoprecipitation (IP) | IP : 0.5-4.0 ug for 1.0-3.0 mg of total protein lysate |
| Immunohistochemistry (IHC) | IHC : 1:50-1:500 |
| It is recommended that this reagent should be titrated in each testing system to obtain optimal results. | |
| Sample-dependent, Check data in validation data gallery. | |
Published Applications
| WB | See 4 publications below |
| IHC | See 4 publications below |
| IF | See 2 publications below |
Product Information
22030-1-AP targets iPLA2 in WB, IHC, IF, IP, ELISA applications and shows reactivity with human, mouse samples.
| Tested Reactivity | human, mouse |
| Cited Reactivity | human, mouse, rat |
| Host / Isotype | Rabbit / IgG |
| Class | Polyclonal |
| Type | Antibody |
| Immunogen |
CatNo: Ag16896 Product name: Recombinant human PLA2G6 protein Source: e coli.-derived, PET28a Tag: 6*His Domain: 1-343 aa of BC036742 Sequence: MQFFGRLVNTFSGVTNLFSNPFRVKEVAVADYTSSDRVREEGQLILFQNTPNRTWDCVLVNPRNSQSGFRLFQLELEADALVNFHQYSSQLLPFYESSPQVLHTEVLQHLTDLIRNHPSWSVAHLAVELGIRECFHHSRIISCANCAENEEGCTPLHLACRKGDGEILVELVQYCHTQMDVTDYKGETVFHYAVQGDNSQVLQLLGRNAVAGLNQVNNQGLTPLHLACQLGKQEMVRVLLLCNARCNIMGPNGYPIHSAMKFSQKGCAEMIISMDSSQIHSKDPRYGASPLHWAKNAEMARMLLKRGCNVNSTSSAGNTALHVAVMRNRFDCAIVLLTHGANA Predict reactive species |
| Full Name | phospholipase A2, group VI (cytosolic, calcium-independent) |
| Calculated Molecular Weight | 90 kDa |
| Observed Molecular Weight | 80-90 kDa |
| GenBank Accession Number | BC036742 |
| Gene Symbol | PLA2G6 |
| Gene ID (NCBI) | 8398 |
| RRID | AB_2878976 |
| Conjugate | Unconjugated |
| Form | Liquid |
| Purification Method | Antigen affinity purification |
| UNIPROT ID | O60733 |
| Storage Buffer | PBS with 0.02% sodium azide and 50% glycerol, pH 7.3. |
| Storage Conditions | Store at -20°C. Stable for one year after shipment. Aliquoting is unnecessary for -20oC storage. 20ul sizes contain 0.1% BSA. |
Background Information
PLA2G6, also named as PLPLA9, is involved in the remodeling of membranes allowing arachidonic acid to be placed in the proper position in phospholipids for stimulated release. It has been implicated in normal phospholipid remodeling, nitric oxide-induced or vasopressin-induced arachidonic acid release and in leukotriene and prostaglandin production. This protein has 4 isoforms produced by alternative splicing.
Protocols
| Product Specific Protocols | |
|---|---|
| IHC protocol for iPLA2 antibody 22030-1-AP | Download protocol |
| IP protocol for iPLA2 antibody 22030-1-AP | Download protocol |
| WB protocol for iPLA2 antibody 22030-1-AP | Download protocol |
| Standard Protocols | |
|---|---|
| Click here to view our Standard Protocols |
Publications
| Species | Application | Title |
|---|---|---|
Adv Sci (Weinh) Role of SLC16A10 in Psoriasis Through the Regulation of Arachidonic Acid Metabolism in Keratinocytes | ||
Cell Rep Alpha synuclein determines ferroptosis sensitivity in dopaminergic neurons via modulation of ether-phospholipid membrane composition | ||
J Agric Food Chem Inhibitory Effects of Peroxidase from Foxtail Millet Bran on Colitis-Associated Colorectal Carcinogenesis by the Blockage of Glycerophospholipid Metabolism. | ||
Neurol Res Calcium-independent phospholipase A2 inhibitor produces an analgesic effect in a rat model of neuropathic pain by reducing central sensitization in the dorsal horn. | ||
Zhongguo Dang Dai Er Ke Za Zhi [Clinical features of infantile neuroaxonal dystrophy and PLA2G6 gene testing]. | ||
Exp Neurol iPLA2β/p38 MAPK alleviates the blood brain barrier disruption and brain injury in rats after TBI by inhibiting autophagy and tight junction damage: In vitro and in vivo studies |